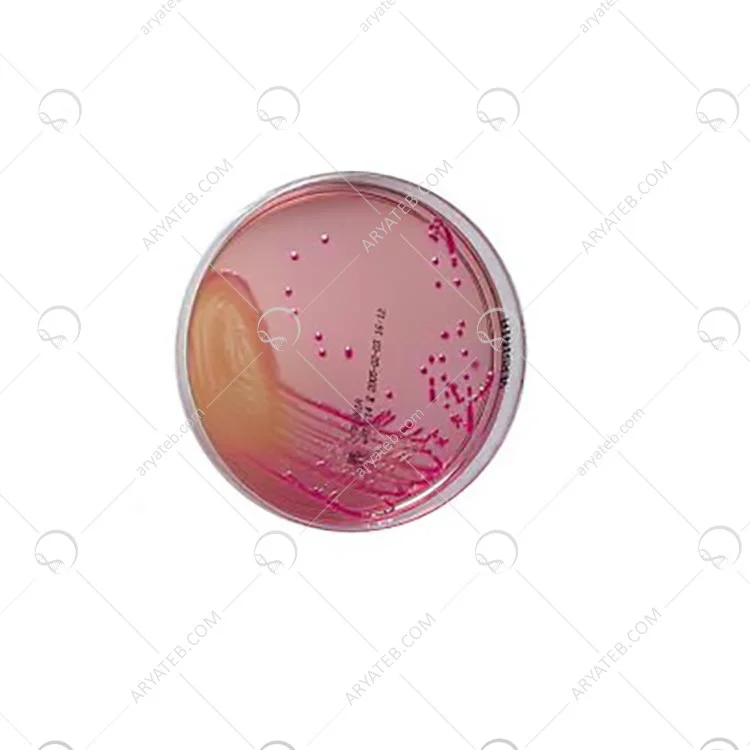

محیط کشت cin
محیط کشت CIN یک محیط افتراقی و انتخابی است که در روش های کیفی برای جداسازی یرسینیا انتروکولیتیکا از نمونه های مختلف بالینی و غیر بالینی استفاده می شود. با کاهش غلظت سفسولودین می توان از CIN Agar برای جداسازی انتخابی آئروموناس نیز استفاده کرد. بودن.
محیط کشت میکروبی یرسینیا آگار
محیط کشت میکروبی Yersinia CIN Agar یک محیط انتخابی برای جداسازی و تمایز یرسینیا انتروکولیتیکا از نمونه های بالینی و غذایی است.
در حال حاضر بیشتر بیماری های انسانی ناشی از یرسینیا به دلیل نوع انتروکولیتیکی آن است. این ارگانیسم باعث بیماری عفونی یرسینیوز می شود و تب، درد شکم و اسهال از علائم این بیماری است.
یکی دیگر از پاتوژن های مهم این گونه، Y. pseudotuberculosis است که علائم آن به جز اسهال مشابه علائم Y. enterocolitica است. بیشتر عوامل عفونی از طریق غذاهای آلوده مانند گوشت خوک خام یا نیم پز، غذاهای دریایی، سبزیجات، شیر پاستوریزه نشده و آب تصفیه نشده منتقل می شوند.
.jpg)
محیط کشت Yersinia selective agar
اجزای غذایی این محیط شامل انواع پپتون ها و عصاره هایی است که باعث رشد باکتری ها می شود. ترکیبی از مانیتول و قرمز خنثی خاصیت متمایزکننده ای در این محیط ایجاد می کند. ارگانیسمهایی که قادر به تخمیر مانیتول هستند، pH اطراف کلنی تخمیر را کاهش میدهند، که رنگ را جذب میکند و به این کلنیها رنگ قرمز-قرمز خنثی میدهد. سیتروباکتر، Enterobacter agglomerans و Serratia liquefaciens می توانند کلنی های مشابهی تولید کنند که باید از سایر آزمایشات بیوشیمیایی متمایز شوند.
محیط کشت میکروبی Yersinia CIN Agar
ارگانیسم هایی که قادر به تخمیر مانیتول هستند PH اطراف کلنی را کاهش می دهند و رنگ قرمز خنثی به کلنی تبدیل می شود که قرمز به نظر می رسد. به دلیل کاهش pH موضعی، ممکن است ناحیه ای از صفرای رسوبی نیز وجود داشته باشد. ظاهر کلنی ها شبیه به "چشم گاو" است. ارگانیسم هایی که مانیتول را به اسید متابولیزه نمی کنند، کلونی های شفاف و بی رنگ تولید می کنند.
فرومولاسیون محیط کشت cin agar
مانیتول
پپتون (منبع کربن و نیتروژن)
پپتون پروتئاز (منبع کربن و نیتروژن)
عصاره مخمر (ویتامین های B و غیره)
سدیم پیروات (محرک رشد گونه های یرسینیا)
NaCl (حفظ تعادل اسمزی محیط)
دی اکسی کولات سدیم (از رشد باکتری های گرم مثبت و بسیاری از باکتری های گرم منفی جلوگیری می کند)
کلات سدیم (از رشد باکتری های گرم مثبت و گرم منفی جلوگیری می کند)
قرمز خنثی (نشانگر pH)
MgSO4 (تحریک رشد یرسینیا)
ایرگاسان (از باکتری های گرم مثبت و بسیاری از باکتری های گرم منفی جلوگیری می کند)
سپسولودین (فلور طبیعی باکتری های روده را مهار می کند)
نووبیوسین (فلور طبیعی باکتری های روده را مهار می کند)
کریستال بنفش (از رشد باکتری های گرم مثبت و بسیاری از باکتری های گرم منفی جلوگیری می کند)
آگار (ژل زا)
H2O
برای دیدن مواد آزمایشگاهی بیشتر کلیک کنید.
آدرس ایمیل شما منتشر نخواهد شد. فیلدهای الزامی علامت گذاری شده اند *